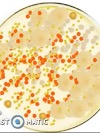
AVATAR

Patología molecular
|
|
Título del Test:
 Patología molecular Descripción: Test para estudiar el examen de patología |



| Comentarios |
|---|
NO HAY REGISTROS |
|
¿Cuál de las siguientes enfermedades de herencia mendeliana es más frecuente?. Citrulinemia tipo II. Hipercolesterolemia familiar. Mucopolisacaridosis. Acidemia propiónica. Fibrosis quística. ¿Cuál de las siguientes enfermedades NO está causadas por mutaciones en transportadores de metabolitos?. Adrenoleucodistrofia. Enfermedad de Hartnup. Enfermedad de Gaucher. Cistinuria tipo I. Citrulinemia tipo II. ¿Cuál de las siguientes enfermedades NO es lisosomal?. Enfermedad de Niemann-Pick. Enfermedad de Tay-sachs (deficiencia de hexo…. Enfermedad de Gaucher. Glucogenosis Tipo I (Von Gierke o deficiencia de glucosa-6-fosfatasa). Enfermedad de Fabry (deficiencia de α-galactosidasa A). ¿Cuál de las siguientes opciones triples es correcta en relación con la región en la que parecen las expansiones de tripletes en las siguientes enfermedades: En el promotor En la región codificante En la región 3' UTR. Síndrome X frágil Distrofia miotónica Huntington. Distrofia miotónica Huntington Síndrome X frágil. Huntington Síndrome X frágil Distrofia miotónica. Síndrome X frágil Huntington Distrofia miotónica. Distrofia miotónica Síndrome X frágil Huntington. Un obrero de una fábrica ha sufrido pérdida auditiva. Otros miembros de su familia con pérdida de oído presentan una mutación conocida en un gen relacionado con sordera. Sin embargo, cuando el obrero es analizado, no se encuentra mutación en ese locus familia. ¿Cómo puede explicarse?. Dominancia incompleta. Penetrancia reducida. Expresividad variable. Heterogeneidad de locus. Expresividad variable. En un ensayo de ligamiento múltiple para identificar el gen responsable de la atrofia muscular al cromosoma X (XL-SMA) encuentran los resultados de la figura usando el programa Allegro. Indica de las siguientes interpretaciones cuál es la correcta: Se encuentran dos posibles regiones candidatas coincidentes con los marcadores DXS8080 y DXS1194. Se encuentran ligamiento con marcadores en la región flanqueada por los marcadores DXS8080 y DXS1194. No se puede determinar la existencia de ligamiento al encontrar valores de LOD idénticos para un gran número de marcadores. No se puede determinar la existencia de ligamiento con este análisis, se necesitaría completarlo con otros marcadores. El análisis indica que en la región comprendida entre los marcadores DXS8080 y DXS1194 existirían 6 genes candidatos causantes de XL-SMA. Un marcador microsatélite de tipo dinucleótido localizado en el cromosoma 2q es amplificado por PCR a partir de ? aislado de un tumor de colon y de sangre periférica del mismo paciente. Los productos de PCR son analizados mediante un electroferograma y el resultado se muestra en la figura (Izq. DNA control; derecha DNA del tumor; los números en la escala horizontal marcan el tamaño de la repetición en nucleótidos). ¿Cuál de las siguientes causas explican mejor qué le ha ocurrido al marcador?. Inestabilidad del marcador microsatélite en el DNA del tumor. Pérdida de heterocigosidad (LOH) en el marcador microsatélite en el DNA del tumor. Expansión del microsatélite en el DNA de la línea germinal. Delección de las dos copias del microsatélite en el DNA del tumor. A que el paciente ha recibido un trasplante de médula. Indica de las siguientes afirmaciones cuál ES correcta en relación con las hemogoblinopatías estructurales: Las mutaciones causan siempre la disminución o ausencia de alguna de las cadenas de globinas. Se han descrito más de 800 variantes de hemoglobina todas ellas patogénicas. Mutaciones localizadas en diferentes regiones estructurales de las globinas afectan de forma similar a su funcionalidad. Algunas variantes patogénicas se encuentran en alta frecuencia en algunos grupos étnicos del norte de África y del sudeste asiático. La variante de hemoglobinopatía más frecuente es la denominada Constant Spring. En relación a la persistencia hereditaria de hemoglobina fetal (HPFH) que característica NO es cierta. Se caracteriza por la ausencia o reducción de la expresión de los genes de δ y β globinas. Es una patología menos grave que las β-talasemias. En HPFH existe un genotipo más leve que en β-talasemias por el efecto protector de la expresión sostenida de γ-globina. Las mutaciones presentes en individuos con HPFH impiden la represión postnatal de la expresión del gen de γ-globina en el adulto. HPFH es más frecuente que las β-talasemias en la población caucásica. La enfermedad de von Willebrand es un trastorno hemorrágico que. Está producido por mutaciones en las diferentes proteínas que forman el complejo de von Willebrand. Impide la lisis de las plaquetas circulantes en regiones de daño vascular. Es el trastorno hemorrágico más frecuente en humanos, su prevalencia es del 1-2% de la población. Es un carácter recesivo ligado al cromosoma X. Los enfermos de este síndrome deben ser sometidos a un trasplante de médula. En relación con Galactosemia indica qué dato ES correcto. Se trata de una enfermedad causada por defectos en la absorción de galactosa en el intestino. La causan mutaciones en las enzimas que transforman galactosa en glucosa-1-fosfato para su degradación. La gravedad de la enfermedad depende únicamente del acúmulo de galactosa en sangre. En los enfermos de la forma más severa de galactosemia se han detectado mutaciones en al menos dos de las enzimas que intervienen en su degradación: GALT, GALK y GALE. Tiene una herencia autonómica dominante. En el pedigrí que se muestra a continuación, la individuo I-2 se le acaba de diagnosticar MELAS. En qué individuo NO existe ningún riesgo de desarrollar la enfermedad. II-1. II-2. III-1. III-2. III-3. La hipercolesterolemia familiar puede ser causada por un defecto en. Receptor de LDL. El transportador de membrana plasmática ABCA1. La lipasa hepática. ApoE. Por mutaciones en cualquiera de las proteínas anteriores. En relación a la enfermedad de jarabe de Arce (MSUD) indica que dato NO es correcto. Los pacientes muestran descompensación metabólica. En los casos más graves se produce la muerte a los pocos días de nacer. Los pacientes presentan elevados niveles de los aminoácidos leucina, valina, isoleuciona en plasma. La enfermedad es producida por mutaciones en una única enzima mitocondrial con actividad α-cetoácido deshidrogenasa. Los pacientes de MSUD pueden ser tratados con dietas pobres en aminoácidos de cadena ramificada. 16. La hiperamonemia característica de los defectos en los genes del ciclo de la urea desencadena en los pacientes. Daño haploico?. Daños en el riñón al liberarse a través de los túbulos renales. Trastornos hormonales al afectar a la liberación dopamina en el cerebro. Un trastorno neuropsiquiátrico severo que conduce progresivamente a un alterado estatus mental y de coma. La retro-inhibición del ciclo de la urea en los hepatocitos y su inflamación. La gravedad del fenotipo en las enfermedades provocadas por mutaciones en el DNA mitocondrial va a depender principalmente. Un tipo de mutación en el DNA mitocondrial. El grado de heteroplasmia de la mutación. El tamaño de la deleción que presenta el DNA mitocondrial. El efecto de otros genes nucleares que codifican para proteínas mitocondriales. El daño masivo en el DNA mitocondrial. El origen de la patología observada en los síndromes mitocondriales MELAS y MERRF se debe a: A la degradación de DNA mitocondrial. A alteraciones en la entrada de proteínas nucleares a la mitocondria. A la alteración del reconocimiento codón-anticodón. A mutaciones en los nucleótidos del anticodón de tRNAs mitocondriales. A la alteración de la transcripción de los genes mitocondriales. En relación con CFTR (regulador de la conductancia transmembranal de la fibrosis quística), cuál de las siguientes afirmaciones NO es cierta. Todas las mutaciones en el gen CFTR alteran su capacidad transportadora de la proteína. Los individuos con mutaciones en CFTR se caracterizan por la presencia de iones Cl- en el sudor, insuficiencia pancreática e infecciones pulmonares recurrentes. La activación del canal se regula por fosforilación mediada por PKA que permite que los dominios de unión a nucleótidos se expongan e hidrolicen ATP lo que favorece el transporte de Cl-. La correlación genotipo/fenotipo de las diferentes mutaciones es distinta en los diferentes órganos afectados. En Europa una de las mutaciones más frecuente en CFTR es ∆F508. Origen de la inmunodeficiencia severa combinada (SCID) causada por deficiencia en adenosina deaminasa (ADA). A la inhibición de la síntesis de DNA causada en timocitos y linfocitos B por la acumulación selectiva de dATP. A la alteración de los procesos de recombinación en el DNA necesarios para generar anticuerpos. El incremento de adenosina anula el control de retro-inhibición sobre la síntesis de novo de nucleótidos. A la activación de la enzima ribonucléotido-reductasa encargada de la degradación de nucleósidos. Al aumento de los niveles de ácido úrico. La afectación neurológica en la enfermedad de Lesch-Nyman se debe a. Que se trata de una enfermedad recesiva ligado al cromosoma X. Al incremento de la actividad de la enzima hipoxantina-guanina fosforribosiltransferasa (HPRT). A la desregulación de las reacciones de síntesis de novo de nucleósidos. Incremento de los niveles de ácido úrico en orina. Al incremento de los niveles de dGTP. De las siguientes enfermedades en cuál NO están afectadas los niveles de neurotransmisores en el SNC. Tirosinemia. Enfermedad de Hartnup. Fenilcetonuria. Jarabe de Arce (MSUD). Enfermedad de Refsum. La característica patológica común para todas las enfermedades mitocondriales es. La presencia de deleciones en el DNA mitocondrial. Alteraciones en los procesos de fosforilación oxidativa. Aparición de alteraciones en la forma de las mitocondrias. Alteraciones en los tRNAs mitocondriales. La aparición de daños en la retina. En las enfermedades lisosomales de acumulo el tipo de terapia que NO se utiliza es. El transplante del órgano afectado. Terapia de re-emplazamiento enzimático “ERT”. Terapia de reducción de sustrato. Terapia con chaperones químicos. Trasplante de médula osea. En relación con Cistinuria, cuál de las siguiente afirmaciones ES cierta. Afecta a la reabsorción de aminoácidos di-básicos: ornitina, lisina, arginina y cistina en los túbulos renales proximales y el tracto gastrointestinal. Se debe a mutaciones en las dos subunidades del transportador de aminoácidos b, SLC3A1 y SLC7A9, las cuales son muy similares estructuralmente. Los pacientes presentan cálculos biliares. Se produce por mutaciones en un trasportador de cisteína dependiente de Na+. La mayoría de pacientes pueden mantenerse asintomáticos si tienen una dieta rica en proteínas. Cuál sería el genotipo de un paciente de fibrosis quística heterocigoto compuesto para una mutación de tipo V (suave) y una mutación de tipo I como G45stop. Severo. Moderado. No manifiesta ningún fenotipo. Suave. El fenotipo del heterocigoto dependerá del tejido afectado. La diferencia principal entre la distrofia muscular de Duchenne (DMD) y la de Becker (BMD) reside en: La edad de aparición del fenotipo de distrofia muscular. En BMD las deleciones en el gen de distrofia mantiene la fase de lectura y en DMD. DMD es una enfermedad ligada al cromosoma X mientras que BMD es autosómica recesiva. Solo BMD puede ser tratada con terapia génica de oligonucleótidos antisentido. Ninguna de las opciones anteriores es correcta. A qué se deben las principales manifestaciones clínicas del síndrome de Hartnup. Al defecto en el transporte de aminoácidos alifáticos largos en el intestino. Al defecto en el transporte intestinal de triptófano. Al defecto de la captura de triptófano en el riñón únicamente. Al exceso de serotonina provocado por el incremento en los niveles de triptófano. A la dieta rica en proteínas con alto contenido en triptófano de los países más desarrollados. La terapia con antibióticos aminoglicósidos como gentamicina es útil en los pacientes de DMD (distrofia muscular de Duchenne) porque…. Disminuye la entrada de calcio extracelular evitando la necrosis de la fibra muscular. Permite la lectura de codones de parada durante la traducción de los mRNAs mutados. Incrementa la actividad de la enzima creatina kinasa favoreciendo la contracción muscular. Favorece la síntesis de proteínas truncadas en los ribosomas. Incrementa la frecuencia de inicio de la síntesis de proteínas por los ribosomas. Cuál de las siguientes afirmaciones respecto a la progresión tumoral NO es correcta. Durante la progresión hacia estadios más malignos aparecen mutaciones en oncogenes y anti-oncogenes. La adquisición de un fenotipo maligno siempre requerirá la mutación del gen p53. En estadios tardios se detectan más lesiones genéticas que en etapas tempranas. Las mutaciones tempranas son más críticas para el desarrollo del tumor que mutaciones que tienen lugar más tarde. En tumores de un mismos tipo es frecuente encontrar mutaciones en genes distintos pero relacionados funcionalmente. Donde reside la diferencia(s) entre el síndrome de Cockayne (SC) y xeroderma pigmentosum (XP). Los pacientes de SC muestran un patrón de herencia autosómica dominante y los de XP no. En SC está afectado el mecanismo de reparación e DNA NER acoplado a la transcripción y en XP está afectado el mecanismo de reparación NER del DNA que no se transcribe. Los pacientes de CS no presentan cáncer de piel a pesar de la foto sensibilidad y los de XP si. Los pacientes de CS presentan síntomas neutrológicos y los de XP no. De las siguientes afirmaciones sobre los genes supresores de tumores indica cual NO es correcta. Los genes supresores de tumores son silenciados por metilación. La aparición de un tumor requiere la perdida de las dos copias funcionales del gen supresor. El mecanismo principal de mutaciones de estos genes supresores es la aparición de codones de parada de la traducción. El primer gen supresor de tumores identificado fue el gen retinoblastoma (RB). Los análisis de pérdida de heterocigosidad (LOH) en tumores han permitido la identificación de numerosos genes supresores. En relación con los procesos de angiogénesis indica que afirmación NO es correcta. La angiogénesis tumoral supone la proliferación de vasos sanguíneos en la masa tumoral para favorecer el aporte de nutrientes y oxígeno. En las células endoteliales activadas se secretan metaloproteínasas de matriz (MMPs) que favorecen la angiogénesis. Existen diferentes moléculas endogénas que inhiben la angiogénesis, destacando VEGF y bFGF. Los inhibidores de la angiogénesis bloquean la capacidad de la célula endotelial de degradar la matriz extracelular. La inhibicón de la angiogénesis es uno de los objetivos en los tratamientos contra cáncer. Las neuropatías producidas por expansiones de tripletes CAG. Se deben siempre a mutaciones que aparecen de novo en la línea germinal. Produce la aparición de regiones ricas en prolina que alteran el plegamiento de la proteína. La longitud de la expansiones se correlaciona con la gravedad de los síntomas. Las enfermedades más comunes producidas por expansiones de CAGs son la enfermedad de Huntington y la distrofia muscular de Becker (BMD). Cuando se generan en la región 3’-UTR provocan la inestabilidad del mRNA del gen. En relación con el síndrome de Zellweger. En las células afectadas se observan defectos en la biogénesis peroxisomal. En zellweger se han encontrado mutaciones en al menos 13 genes denominados PEXs. En los fibroblastos de los pacientes se observa la aparición de peroxisomas “fantasmas”. En los pacientes de este síndrome están alterados los principales procesos metabólicos peroxisomales. Todas son ciertas. Ninguna es cierta. Cuál de las siguientes funciones es principalmente realizada por los receptores “scavengers”?. Receptor de HDL en el hígado y tejidos que sintetizan esteroides. Se encargan de la secreción de colesterol celular para formar HDL. Regulan los niveles de LDLR al inducir su degradación. Receptor de HDL y VLDL en el hígado. Se encuentran en invaginaciones recubiertas y clatrina favoreciéndola formación de endosomas. Tras realizar la secuenciación de los exones del individuo IV:II que presenta ceguera, los técnicos del laboratorio le indican al genetista responsable que han encontrado la mutación c.1024delC en el gen eyeless en heterocigosis, y que por tanto sería la causante del fenotipo observado. El genetista no lo cree posible ¿por qué?. Considera que debería tratarse de un factor de transcripción y eyeless no lo es. La deleción de 1 nucleótido no causa una alteración grave en la proteína. La mutación debe ser de novo y no es frecuente ese tipo de deleción en la línea germinal. No es esperable que una mutación en heterocigosis cause esa enfermedad en la familia analizada. No se fía de sus técnicos, la deleción de 1 nucleótido con frecuencia se debe a errores en la secuenciación. El siguiente cromatograma muestra los resultados obtenidos de la secuenciación de un producto amplificación de DNA genómico por PCR. ¿Cuál de las siguientes interpretaciones es la más compatible con el resultado obtenido?. Heterocigoto para la deleción de un par de bases. Homocigoto para la sustitución de un par de bases. Heterocigoto para la sustitución de un par de bases. Homocigoto para la deleción de un par de bases. Fallo en la reacción de amplificación por PCR. A continuación se muestran los cromatogramas correspondientes a la secuencia de un determinado gen para dos padres sanos y su hijo afectado por un raro trastorno metabólico. Atendiendo a esos resultados, indica de las siguientes afirmaciones cuál es más improbable: Ambos padres son heterocigotos para una mutación de cambio de fase de lectura. La secuencia que se muestra corresponde a una región del cromosoma X. El niño afectado es homocigoto para una duplicación de 2 pares de bases. El trastorno metabólico muestra un patrón de herencia recesivo. Los padres son primos hermanos. De las secuencias mostradas en los siguientes cromatogramas de un paciente y un individuo control normal. ¿Cuál de las siguientes afirmaciones puede ser excluida?. El DNA del paciente ha sufrido una transversión de C por A. La mutación crea un codón de parada. El paciente es heterocigoto para el cambio en la secuencia. El cambio de secuencia observado en el paciente no representa un SNP. El cambio de secuencia puede no ser deletéreo. La mutación c.1601G>A en el factor V de Leiden destruye un sitio de restricción para la enzima MnlI. La mutación puede ser detectada amplificando una región de 267 del gen que contiene el sitio de restricción y otro para esa enzima siendo los fragmentos normales para MnlI de 163, 67 y 37. A continuación se muestran los resultados obtenidos tras la amplificación y digestión con la enzima de tres pacientes. De los resultados obtenidos ¿cuál es el genotipo de cada paciente?. Paciente A: G/G Paciente B: G/A Paciente C: A/A. Paciente A: G/A Paciente B: A/A Paciente C: G/G. Paciente A: A/A Paciente B: G/A Paciente C: G/G. Paciente A: G/A Paciente B: G/G Paciente C: A/A. Paciente A: A/A Paciente B: G/G Paciente C: G/A. Se ha diseñado un ensayo de PCR para detectar deleciones grandes en el cluster de los genes de alpha-globinas, el origen más común de las talasemias mediterráneas. En el ensayo se utilizan 2 primers que flanquean la deleción. Así cuando la deleción está presente se amplifica un fragmento de 320 nt, que está ausente cuando no hay deleción. A continuación de muestran los resultados obtenidos para 3 pacientes con los correspondientes controles De los datos obtenidos, qué puede concluirse;. Los Pacientes A y C son heterocigotos para la deleción. Los pacientes A y C son homocigotos para la deleción. El paciente B no presenta la deleción ni en heterocigosis ni en homocigosis. En la reacción llevada en paralelo como control positivo no se puso DNAE). Ninguna de las anteriores. Ensayos de un western blot en extractos de músculo pueden utilizarse para el análisis de alteraciones estructurales en distrofina. En el ensayo mostrado a continuación se han utilizado anticuerpos específicos contra los dominios amino (N) y carboxilo (C) de distrofina (su tamaño normal es de 427 kDa). Basándole en los resultados obtenidos, indica que opción NO es posible: La muestra A es de una mujer cuyo hermano tiene distrofia muscular de Becker (BMD). La muestra A es de un padre cuyo hijo tiene distrofia muscular de Becker. La muestra B es de un chico afectado por distrofia muscular de Becker. La muestra C es de una madre cuyo hijo tiene distrofia muscular de Becker. La muestra C es de un padre cuyo hijo tiene distrofia muscular de Becker. En un ensayo diseñado para detectar la mutación p.C282Y en el gen HFE se amplifica mediante PCR un fragmento genómico de 357 nt. En el alelo normal la digestión de este fragmento con la enzima RsaI produce dos fragmentos de 250 y 107 nt, mientras que la mutación p.C282Y introduce una diana extra para ese enzima en el fragmento de 107 nt. De las muestras analizadas ¿cuál será heterocigota para la mutación p.C282Y?. Muestra 1. Muestra 2. Muestra 3. Muestra 4. Muestra 5. Un bebé de 1 año (II-3) presenta el síndrome de Pearson. Sus padres son sanos así como sus hermanos mayores (II-I y II-2) y su hermano recién nacido (II-4). Se aísla DNA total de linfocitos de sangre periférica de los miembros de la familia y se analiza mediante Southern blot. El DNA se digiere con la enzima PvuII que corta en 1 posición en el DNA mitocondrial. El southern es hibridado con una sonda de DNA mitocondrial y los resultados se muestran a continuación. Basándote en los resultados obtenidos, indica que NO es correcto: La mutación observada en II-3 puede haberse originado en su abuelo materno. Es improbable que los individuos II-1 y II-2 desarrollen el mismo trastorno que su hermana. El individuo II-4 podría presentar el síndrome de Pearson. El individuo II-3 presenta una deleción de 5 kb en su genoma mitocondrial. El defecto genético que presenta II-3 ha sido heredado de su madre. Se ha descrito que mutaciones en el gen DOCK7 producen CKS, un síndrome distrófico autosómico recesivo, con alta prevalencia en población caucásica. Se ha analizado la presencia de mutaciones en el gen DOCK7 en una familia irlandesa que se muestra en el pedigrí. Se muestran también los cromatogramas de la región afectada por las mutaciones encontradas, basándote en ellos indica de las siguientes opciones respecto cuál es la más correcta. Todos los individuos son sanos al ser una enfermedad autosómica recesiva. Todos los individuos son sanos al tratarse de mutaciones diferentes en heterocgosis. Solo el individuo II.1 presentará la enfermedad. Los individuos I.1, I.2 y II.1 y presentarán la enfermedad. Los individuos I.1 y I.2 presentarán una forma más leve de la enfermedad. En un análisis en un paciente de DMD (distrofia muscular de Duchenne) por la técnica MLPA obtienen el siguiente resultado, ¿qué mutación más probable ha tenido lugar?. Mutaciones puntuales en los exones 6, 8 y 10. Deleción de la región comprendida entre los exones 6 y 10. Con los datos obtenidos no se puede determinar la mutación presente. El paciente presenta una mutación en el exón 5 que afecta al splicing del gen de distrofina. En un ensayo de análisis de ligamiento múltiple para identificar el gen responsable de la atrofia muscular infantil ligada al cromosoma X (XL-SMA) encuentran los resultados de la figura usando el programa Allegro. Indica de las siguientes interpretaciones cuál es la correcta: Se encuentran dos posibles regiones candidatas coincidentes con los marcadores DXS8080 y DXS1194. Se encuentran ligamiento con los marcadores de la región flanqueada por los marcadores DXS8080 y DXS1194. No se puede determinar la existencia de ligamiento al encontrar valores de LOD idénticos para un gran número de marcadores. No se puede determinar la existencia de ligamiento con este análisis se necesitaría completarlo con marcadores microsatélites. El análisis indica que en la región comprendida entre los marcadores DXS8080 y DXS1194 existirían 6 genes candidato causantes de XL-SMA. Se realiza una prueba ASO a varios pacientes de fibrosis quística para la mutación F508. Atendiendo a los resultados obtenidos indica la conclusión correcta. Sólo el individuo 6 presentará la enfermedad. Los individuos 1, 7 y 9 presentarán la enfermedad. Los individuos 3, 6 y 7 no presentarán la enfermedad al mostrar bajos o nulos niveles de hibridación con el oligo F508. Todos los individuos menos 6 presentarán la enfermedad. Sólo los individuos 2, 3, 4, 5 y 8 presentarán la enfermedad. En la figura se muestran los resultados de un análisis CGH (“hibridación genómica comparativa”) de DNA de la línea tumoral HL60 frente a “arrays” correspondientes a los cromosomas 14 y 18. Del resultado obtenido Indica de las siguientes opciones cual es la más correcta. La línea celular HL60 sólo presenta alteraciones en el cromosoma 14. La línea celular HL60 sólo informativo para los genes localizados en el cromosoma X DMD y COL4A5. La línea celular HL60 presenta una trisomía del cromosoma 18. La línea celular HL60 presenta la duplicación de dos regiones del cromosoma 14. La línea celular HL60 presenta una trisomía del cromosoma 18 y la duplicación de los genes NF2 y PMP. En la figura se muestran los resultados de un análisis CGH (“hibridación genómica comparativa”) frente a un “array” conteniendo exones de los genes indicados. En el análisis el DNA de la paciente, una mujer de 45 años, se ha marcado con el fluoróforo Cy5 y como control se ha utilizado el DNA de una mujer marcado con el fluoróforo Cy3. Indica de las siguientes opciones cual es la más correcta. La paciente presenta alteraciones en la región que contiene los genes NF2, PLP y PMP22. El análisis no sería informativo para los genes localizados en el cromosoma X DMD y COL4A5. La paciente presenta la duplicación de los genes NF2 y PMP22. La paciente presenta 4 copias del gen PMP22. Se necesitaría realizar un análisis mediante PCR cuantitativa para determinar las lesiones genéticas de la paciente. En el siguiente pedigrí se muestra la co-segregación de cuatro marcadores del cromosoma 21 con los miembros de una familia que padece esclerosis lateral amiotrófica (ELA) familiar. CUESTION 1. ¿Qué patrón de transmisión presenta ELA en este pedigrí? Justifica claramente tu respuesta. CUESTION 2. Sabiendo que ELA es una enfermedad que aparece en el adulto y basándote en los haplotipos que presentan los individuos jóvenes y aún asintomáticos, IV.1, IV.2, IV.3, IV.4 y IV.5, para los marcadores analizados ¿podrías predecir cuáles de ellos podrán sufrir ELA? Justifica claramente tu respuesta. Varios miembros de una familia marroquí co-sanguínea afectados por una sordera severa iniciada temprano en la infancia y que ha afectado la adquisición normal del habla. Se está analizando a varios miembros de la familia, descartándose inicialmente la presencia de las mutaciones que con mayor frecuencia producen sordera, a continuación se ha realizado un análisis de ligamiento utilizándose marcadores de tipo microsatélite. Los resultados para marcadores localizados en el cromosoma 2 se muestran en el siguiente pedigrí. Basándote en los datos mostrados en la figura, contesta a las siguientes preguntas, justifica adecuadamente todas tus respuestas. CUESTION 1 Indica el patrón de herencia más probable CUESTION 2 ¿Entre qué marcadores se encontrará el locus/gen causante de la sordera en esta familia? CUESTION 3 Considera que tienes a tu disposición todas las herramientas en biología molecular desarrolladas hasta ahora. ¿Cuál sería el abordaje/abordajes que desarrollarías para identificar la mutación que causa la sordera en esta familia?. |